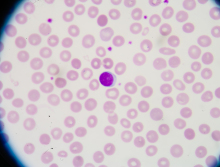

淄博做宫腔镜检查费用解析:价格构成、医院对比及报销指南
2025-05-30 17:20 · 2066人浏览
导语
在淄博地区,宫腔镜检查已成为妇科疾病诊断的重要手段,但许多女性对检查费用、医院选择和报销政策存在困惑。本文深度解析检查费用的核心构成、不同医疗机构收费标准差异,并提供2025年最新医保报销指南,助您以最优成本完成精准诊疗。
一、宫腔镜检查的必要性
当出现异常子宫出血、反复流产或不孕症时,宫腔镜检查能直观观察宫腔形态,准确率高达95%以上。相比传统诊刮术,这种微创技术创口仅3mm,术后恢复周期缩短50%,已成为现代妇科诊断金标准。二、费用核心构成解析
基础检查费:包含宫腔镜设备使用及消毒耗材,淄博三甲医院收费800-1200元
麻醉费用:局部麻醉200-300元,静脉全麻需增加600-800元
附加项目:病理活检单项200-500元,宫腔粘连分离等治疗另计
三、淄博医疗机构收费对比
▷ 三甲医院:2025年指导价1200-1800元(含基础检查+病理)
▷ 专科医院:推出1980元套餐(检查+麻醉+术后护理)
▷ 私立机构:价格浮动较大(1500-3500元),需注意隐性收费
四、医保报销实操指南
门诊检查可报销50%-70%(需携带医保卡实时结算),住院治疗报销比例提升至80%。特殊病种患者通过淄博医保公众号在线提交材料,3个工作日内完成审批。
五、费用优化三大策略
① 选择月经干净后3-7天检查,避免重复支出
② 对比医院套餐时重点查看麻醉方式、术后用药明细
③ 低收入群体可申请淄博市妇女健康援助基金(最高补贴800元)
结语
掌握淄博宫腔镜检查的价格构成与报销政策,不仅能合理规划医疗支出,更能获得精准的诊疗服务。建议根据自身情况选择正规医疗机构,充分利用医保政策,让健康管理更科学、更经济。宫腔镜检查费用
淄博妇科检查
医保报销政策
医院收费标准
大家都在问
试管婴儿助孕交流群




精选
猜您喜欢
试管婴儿 > 试管婴儿资讯 > 淄博做宫腔镜检查费用解析:价格构成、医院对比及报销指南